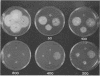

Abstract
A novel strategy was used to develop a transformation system for the plant pathogenic fungus Cochliobolus heterostrophus. Sequences capable of driving the expression of a gene conferring resistance to the antibiotic hygromycin B in C. heterostrophus were selected from a library of genomic DNA fragments and used, with the selectable marker, as the basis for transformation. The library of random 0.5- to 2.0-kilobase-pair fragments of C. heterostrophus genomic DNA was inserted at the 5' end of a truncated, promoterless Escherichia coli hygromycin B phosphotransferase gene (hygB) whose product confers resistance to hygromycin B. C. heterostrophus protoplasts were transformed with the library and selected for resistance. Resistant colonies arose at low frequency. Each colony contained a transformation vector stably integrated into chromosomal DNA. When the transforming DNA was recovered from the genome and introduced into C. heterostrophus, resistant colonies appeared at higher frequency. We determined the sequences of two of the C. heterostrophus DNA fragments which had been inserted at the 5' end of hygB in the promoter library and found that both made translational fusions with hygB. One of the two fusions apparently adds 65 and the other at least 86 amino acids to the N-terminus of the hygB product. Plasmids containing hygB-C. heterostrophus promoter fusions can be used unaltered to drive hygB expression in several other filamentous ascomycetes. This approach to achieving transformation may have general utility, especially for organisms with relatively undeveloped genetics.
Full text
PDF








Images in this article
Selected References
These references are in PubMed. This may not be the complete list of references from this article.
- Biggin M. D., Gibson T. J., Hong G. F. Buffer gradient gels and 35S label as an aid to rapid DNA sequence determination. Proc Natl Acad Sci U S A. 1983 Jul;80(13):3963–3965. doi: 10.1073/pnas.80.13.3963. [DOI] [PMC free article] [PubMed] [Google Scholar]
- Botstein D., Falco S. C., Stewart S. E., Brennan M., Scherer S., Stinchcomb D. T., Struhl K., Davis R. W. Sterile host yeasts (SHY): a eukaryotic system of biological containment for recombinant DNA experiments. Gene. 1979 Dec;8(1):17–24. doi: 10.1016/0378-1119(79)90004-0. [DOI] [PubMed] [Google Scholar]
- Clements J. M., Roberts C. F. Transcription and processing signals in the 3-phosphoglycerate kinase (PGK) gene from Aspergillus nidulans. Gene. 1986;44(1):97–105. doi: 10.1016/0378-1119(86)90047-8. [DOI] [PubMed] [Google Scholar]
- Dale R. M., McClure B. A., Houchins J. P. A rapid single-stranded cloning strategy for producing a sequential series of overlapping clones for use in DNA sequencing: application to sequencing the corn mitochondrial 18 S rDNA. Plasmid. 1985 Jan;13(1):31–40. doi: 10.1016/0147-619x(85)90053-8. [DOI] [PubMed] [Google Scholar]
- Feinberg A. P., Vogelstein B. A technique for radiolabeling DNA restriction endonuclease fragments to high specific activity. Anal Biochem. 1983 Jul 1;132(1):6–13. doi: 10.1016/0003-2697(83)90418-9. [DOI] [PubMed] [Google Scholar]
- Frischauf A. M., Lehrach H., Poustka A., Murray N. Lambda replacement vectors carrying polylinker sequences. J Mol Biol. 1983 Nov 15;170(4):827–842. doi: 10.1016/s0022-2836(83)80190-9. [DOI] [PubMed] [Google Scholar]
- Geck P., Nász I. Concentrated, digestible DNA after hydroxylapatite chromatography with cetylpyridinium bromide precipitation. Anal Biochem. 1983 Dec;135(2):264–268. doi: 10.1016/0003-2697(83)90681-4. [DOI] [PubMed] [Google Scholar]
- Gritz L., Davies J. Plasmid-encoded hygromycin B resistance: the sequence of hygromycin B phosphotransferase gene and its expression in Escherichia coli and Saccharomyces cerevisiae. Gene. 1983 Nov;25(2-3):179–188. doi: 10.1016/0378-1119(83)90223-8. [DOI] [PubMed] [Google Scholar]
- Herman L. M., Van Montagu M. C., Depicker A. G. Isolation of tobacco DNA segments with plant promoter activity. Mol Cell Biol. 1986 Dec;6(12):4486–4492. doi: 10.1128/mcb.6.12.4486. [DOI] [PMC free article] [PubMed] [Google Scholar]
- Horwitz M. S., Loeb L. A. Promoters selected from random DNA sequences. Proc Natl Acad Sci U S A. 1986 Oct;83(19):7405–7409. doi: 10.1073/pnas.83.19.7405. [DOI] [PMC free article] [PubMed] [Google Scholar]
- Lloyd A. M., Barnason A. R., Rogers S. G., Byrne M. C., Fraley R. T., Horsch R. B. Transformation of Arabidopsis thaliana with Agrobacterium tumefaciens. Science. 1986 Oct 24;234(4775):464–466. doi: 10.1126/science.234.4775.464. [DOI] [PubMed] [Google Scholar]
- Mullaney E. J., Hamer J. E., Roberti K. A., Yelton M. M., Timberlake W. E. Primary structure of the trpC gene from Aspergillus nidulans. Mol Gen Genet. 1985;199(1):37–45. doi: 10.1007/BF00327506. [DOI] [PubMed] [Google Scholar]
- Newbury S. F., Glazebrook J. A., Radford A. Sequence analysis of the pyr-4 (orotidine 5'-P decarboxylase) gene of Neurospora crassa. Gene. 1986;43(1-2):51–58. doi: 10.1016/0378-1119(86)90007-7. [DOI] [PubMed] [Google Scholar]
- Osbourn A. E., Barber C. E., Daniels M. J. Identification of plant-induced genes of the bacterial pathogen Xanthomonas campestris pathovar campestris using a promoter-probe plasmid. EMBO J. 1987 Jan;6(1):23–28. doi: 10.1002/j.1460-2075.1987.tb04713.x. [DOI] [PMC free article] [PubMed] [Google Scholar]
- Queen C., Korn L. J. A comprehensive sequence analysis program for the IBM personal computer. Nucleic Acids Res. 1984 Jan 11;12(1 Pt 2):581–599. doi: 10.1093/nar/12.1part2.581. [DOI] [PMC free article] [PubMed] [Google Scholar]
- Santerre R. F., Allen N. E., Hobbs J. N., Jr, Rao R. N., Schmidt R. J. Expression of prokaryotic genes for hygromycin B and G418 resistance as dominant-selection markers in mouse L cells. Gene. 1984 Oct;30(1-3):147–156. doi: 10.1016/0378-1119(84)90115-x. [DOI] [PubMed] [Google Scholar]
- Teeri T. H., Herrera-Estrella L., Depicker A., Van Montagu M., Palva E. T. Identification of plant promoters in situ by T-DNA-mediated transcriptional fusions to the npt-II gene. EMBO J. 1986 Aug;5(8):1755–1760. doi: 10.1002/j.1460-2075.1986.tb04423.x. [DOI] [PMC free article] [PubMed] [Google Scholar]
- Turgeon B. G., MacRae W. D., Garber R. C., Fink G. R., Yoder O. C. A cloned tryptophan-synthesis gene from the ascomycete Cochliobolus heterostrophus functions in Escherichia coli, yeast and Aspergillus nidulans. Gene. 1986;42(1):79–88. doi: 10.1016/0378-1119(86)90152-6. [DOI] [PubMed] [Google Scholar]
- Upshall A., Gilbert T., Saari G., O'Hara P. J., Weglenski P., Berse B., Miller K., Timberlake W. E. Molecular analysis of the argB gene of Aspergillus nidulans. Mol Gen Genet. 1986 Aug;204(2):349–354. doi: 10.1007/BF00425521. [DOI] [PubMed] [Google Scholar]
- Ward J. M., Janssen G. R., Kieser T., Bibb M. J., Buttner M. J., Bibb M. J. Construction and characterisation of a series of multi-copy promoter-probe plasmid vectors for Streptomyces using the aminoglycoside phosphotransferase gene from Tn5 as indicator. Mol Gen Genet. 1986 Jun;203(3):468–478. doi: 10.1007/BF00422072. [DOI] [PubMed] [Google Scholar]